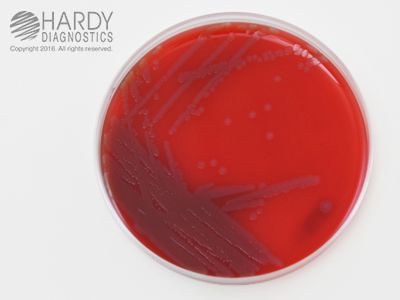

Shibam Agar Plate 15 X 100 Mm For E.Coli , Pack Of 10
$ 91.50
|
|
Details:
SHIBAM Agar 15 x 100 mm plate^ SHIBAM Agar, (BAM recommended) for the detection of Shiga toxin, Used as a selective and differential growth medium for the cultivation of (STEC) Shiga toxin- and enterohemolysin producing E. Coli, Detects enterohemolysin producing E. Coli, Size: 15 x 100 mm plate
Additional Information
| SKU | 24048812 |
|---|---|
| UOM | Pack of 10 |
| UNSPSC | 41106510 |
| Manufacturer Part Number | A146 |
| Product Dimensions | 4X4X8 Inches. |
| Product Weight | 0.8 |
